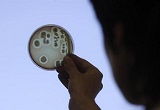
Specialist Jelena Kovalkova works to isolate the Escherichia coli (E.coli) bacteria strain in Riga

Vísindamenn við háskólann í Dundee í Skotlandi hafa komist að því að hinn algengi saurgerill E. coli getur breytt koltvísýringi úr andrúmsloftinu í maurasýru. Við súrefnissnauðar aðstæður myndar bakterían svonefnt FHL-ensím sem gerir þetta efnahvarf mögulegt. Þetta ferli gengur afar hægt fyrir sig við venjulegar aðstæður en sé bakterían sett í blöndu af koltvísýringi og vetni við 10 loftþyngda þrýsting hvarfast allur tiltækur koltvísýringur í maurasýru á skömmum tíma. Þessi uppgötvun kann að opna nýjar leiðir í kolefnisbindingu, enda er maurasýra vökvi sem auðvelt er að geyma og er auk þess nýtanlegur á ýmsan hátt.
Vísindamenn við háskólann í Dundee í Skotlandi hafa komist að því að hinn algengi saurgerill E. coli getur breytt koltvísýringi úr andrúmsloftinu í maurasýru. Við súrefnissnauðar aðstæður myndar bakterían svonefnt FHL-ensím sem gerir þetta efnahvarf mögulegt. Þetta ferli gengur afar hægt fyrir sig við venjulegar aðstæður en sé bakterían sett í blöndu af koltvísýringi og vetni við 10 loftþyngda þrýsting hvarfast allur tiltækur koltvísýringur í maurasýru á skömmum tíma. Þessi uppgötvun kann að opna nýjar leiðir í kolefnisbindingu, enda er maurasýra vökvi sem auðvelt er að geyma og er auk þess nýtanlegur á ýmsan hátt.
(Sjá frétt á heimasíðu Háskólans í Dundee 8. janúar).
Greinasafn fyrir merki: E.coli
Saurgerlar framleiða eldsneyti
Breskir og finnskir vísindamenn hafa þróað aðferð til að láta E. coli bakteríuna framleiða própangas, en E. coli er mjög algengur saurgerill sem finnst í meltingarfærum manna. Própan er aðaluppistaðan í fljótandi jarðolíugasi (LPG) sem notað er sem eldsneyti á bíla, til upphitunar og sem gas fyrir grillið. Framleiðsla própans er hagkvæm að því leyti að víða er til staðar dreifikerfi fyrir efnið. Própan er tiltölulega hreint eldsneyti með lágt kolefnisinnihald og er aukaafurð við hreinsun olíu og vinnslu á jarðgasi. E. coli aðferðin er enn á þróunarstigi, en hún byggir á því að láta bakteríurnar framleiða própan úr fitusýrum sem annars væru notaðar sem byggingarefni í frumuhimnu. Vísindamennirnir vonast til að eftir 5-10 ár verði hægt að nota tæknina til framleiðslu á samkeppnishæfu endurnýjanlegu eldsneyti sem komið getur í stað jarðefnaeldsneytis.
Breskir og finnskir vísindamenn hafa þróað aðferð til að láta E. coli bakteríuna framleiða própangas, en E. coli er mjög algengur saurgerill sem finnst í meltingarfærum manna. Própan er aðaluppistaðan í fljótandi jarðolíugasi (LPG) sem notað er sem eldsneyti á bíla, til upphitunar og sem gas fyrir grillið. Framleiðsla própans er hagkvæm að því leyti að víða er til staðar dreifikerfi fyrir efnið. Própan er tiltölulega hreint eldsneyti með lágt kolefnisinnihald og er aukaafurð við hreinsun olíu og vinnslu á jarðgasi. E. coli aðferðin er enn á þróunarstigi, en hún byggir á því að láta bakteríurnar framleiða própan úr fitusýrum sem annars væru notaðar sem byggingarefni í frumuhimnu. Vísindamennirnir vonast til að eftir 5-10 ár verði hægt að nota tæknina til framleiðslu á samkeppnishæfu endurnýjanlegu eldsneyti sem komið getur í stað jarðefnaeldsneytis.
(Sjá frétt PlanetArk í gær)
